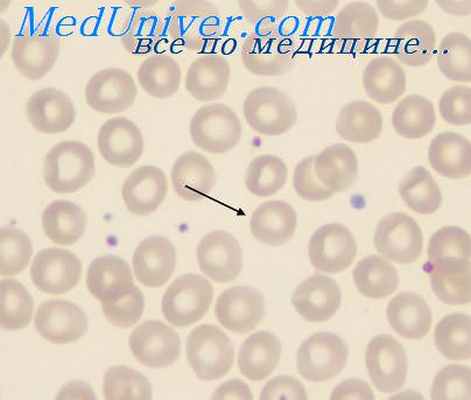
мышьяковистый водород

Хроническое отравление мышьяковистым водородом. Отравление фенилгидразином
Добавил пользователь Алексей Ф. Обновлено: 07.01.2026
Г. обусловленные исключительно или преимущественно воздействием неблагоприятных производственных факторов и условий труда;
3. Основными документами, необходимыми для решения вопроса о связи заболевания с профессией при направлении больного в специализированное профпатологическое учреждение, являются:
Д. подробная выписка из медицинской карты амбулаторного больного с результатами предварительного медицинского осмотра и выписки из истории болезни, если больной находился на стационарном лечении.
4. Для рассмотрения и решения вопроса о наличии профессиональной патологии необходимы все документы, кроме:
8. Расследование случаев острых профессиональных заболеваний (отравлений) проводит комиссия, которую возглавляет:
9. Расследование случаев хронических профессиональных заболеваний проводит комиссия, которую возглавляет:
10. Выяснение обстоятельств возникновения острых профессиональных заболеваний (интоксикаций) осуществляется управлением Роспотребнадзора в сроки:
11. Выяснение обстоятельств возникновения хронических профессиональных заболеваний осуществляется управлением Роспотребнадзора в сроки:
14. При не осложненном силикозе 1-й ст., развившемся через 7 лет после начала контакта с пылью, решение о трудоспособности:
17. Для силикоза и хронического диссеминированного туберкулеза лёгких справедливы все утверждения, кроме:
28. Укажите силикатоз, который даже в 1-й стадии течения, отсутствии осложнений и расстройств ФВД требует перевода больного на другую работу вне контакта с этиологическим фактором:
29. При контакте с пылью цемента, наряду с силикатозом или с силико-силикатозом часто развиваются следующие заболевания:
31. При длительном вдыхании ряда сортов цемента (кислотоупорный, кладочный), содержащего значительное количество свободной двуокиси кремния, развивается пневмокониоз:
Д. отсутствие четкой зависимости между концентрациями бериллия в воздухе и возможностью развития бериллиоза.
Г. постепенное нарастание одышки, сухой приступообразный кашель, боли в грудной клетке, слабость, лихорадка, а также появление небольшого увеличения периферических лимфатических узлов, возможного гранулематозного поражения кожи, печени, селезенки;
В. диффузными интерстициальными мелкопятнистыми образованиями в легких в сочетании с внутригрудной лимфаденопатией;
Б. работа на участках производства, где содержание бериллия в воздухе на уровне ПДК или незначительно превышает ПДК;
41. Пациент Н. 29 лет; 2 года работал на предприятии по производству кинескопов, в настоящее время работает лесником. На фоне ОРЗ и приема антибиотиков отмечено возникновение выраженной одышки, резкое повышение температуры тела, появление кашля. Зафиксировано небольшое увеличение локтевых лимфоузлов. В легких при аускультации определяются мелкопузырчатые хрипы. При рентгенологическом исследовании обнаружены узловые тени в легких. На спирограмме отмечено значительное снижение диффузионной способности легких. Предположительный диагноз:
45. Профессиональные заболевания, которые могут развиться спустя несколько лет после прекращения контакта с производственными факторами:
46. Минимальный стаж работы на вредном производстве в условиях крупнодисперсной пыли, при котором может развиться пылевой бронхит, составляет не менее:
47. Характер поражения слизистых оболочек дыхательных путей наиболее часто встречающийся при пылевых бронхитах:
Б. выбухание мембранозной стенки трахеи и главных бронхов на выдохе, более чем на 1/3 просвета бронха;
Д. нарушение дренажной функции бронхов за счет развития атрофических процессов в реснитчатом эпителии слизистой оболочки бронхов.
Б. выбухание мембранозной стенки трахеи и главных бронхов на выдохе более чем на 1/3 просвета бронха;
В. слизистая оболочка бронхов истончена, с выраженным сосудистым рисунком, с каскадом расширенных устьев бронхиальных желез;
Г. слизистая оболочка бронхов локально гиперемирована, с обильным гнойным секретом в просвете бронха;
53. Для диагностики профессиональной бронхиальной астмы концентрация при работе в контакте с производственным аллергеном:
54. Для диагностики профессиональной бронхиальной астмы по типу атопической информативными признаками являются все, кроме:
55. При диагностике профессиональной бронхиальной астмы смешанного генеза информативными признаками являются все кроме:
56. Укажите вредный производственный фактор из нижеперечисленных, который может являться наиболее частой причиной профессиональной бронхиальной астмы:
А. хлора и его соединений, соединений серы, азота, фтора, хрома, карбонильных соединений, растворимых соединений бериллия;
58. Распространенность и тяжесть поражения бронхолегочной системы токсическими веществами раздражающего действия определяется:
59. Воздействие аэрозолей легкорастворимых токсических веществ на респираторную систему наиболее часто вызывает развитие следующих форм патологии:
60. Воздействие аэрозолей малорастворимых токсических веществ на респираторную систему наиболее часто вызывает развитие следующих форм патологии:
67. Экспертиза трудоспособности больного с профессиональной бронхиальной астмой (атопической) легкой степени:
69. Профессиональные заболевания, для развития которых не требуется длительный стаж работы в условиях воздействия производственной пыли:
71. Информативными признаками для диагностики атопической профессиональной бронхиальной астмы являются:
82. Типичная форма хронической интоксикации бензолом характеризуется поражением функций костного мозга в следующей последовательности:
83. При хронической бензольной интоксикации, прежде всего, поражается функция костномозгового кроветворения:
94. Какие из перечесленных признаков, наиболее характерны для поражения системы крови при интоксикации свинцом?
100. В случае полной обратимости клинических проявлений при острой интоксикации тетраэтилсвинцом правильным экспертным решением является:
101. Развитие лейкозов при промышленных интоксикациях наиболее часто происходит вследствие длительного контакта:
102. В больницу доставлен больной, рабочий бензосмесительной станции, в состоянии спутанного сознания. Больной высказывал бредовые идеи, имели место слуховые и зрительные галлюцинации, временами агрессивен, недоверчив к окружающим, пытался бежать, сопротивляется обследованию. После оказания первой помощи больной успокоился. Из анамнеза известно: имел контакт с этилированным бензином. Объективно: нистагм, легкая асимметрия носогубных складок, симптом Бабинского и Россолимо с обеих сторон. Походка атаксическая. Не устойчив в позе Ромберга, выраженный тремор пальцев рук. Гипергидроз, гиперсаливация. АД 100/50 мм рт. ст. ЧСС – 52 удара в 1 минуту. Наиболее вероятный диагноз:
107. Определите последовательность звеньев патогенеза при остром отравлении пестицидами, содержащими фосфорорганические соединения: 1) нарушение нервного импульса; 2) накопление ацетилхолина; 3) угнетение активности холинэстеразы; 4) центральные и периферические холинэргические эффекты.
108. Неправильным утверждением относительно острого отравления пестицидами, содержащими фосфорорганические соединения, является:
109. У работницы отделения дезинфекции управления Роспотребнадзора, имевшей контакт с хлорофосом и карбофосом, поставлен диагноз: острая интоксикация фосфорорганическими соединениями легкой степени. Экспертная комиссия по трудоустройству принимает решение:
Д. по выдаче листа временной нетрудоспособности, определению процента утраты трудоспособности и установлению группы инвалидности.
110. Неправильным утверждением относительно отравления пестицидами, содержащими хлорорганические соединения, являются:
Д. при вдыхании хлорорганических соединений наблюдаются токсические поражения верхних дыхательных путей.
111. К медикаментозным средствам патогенетической терапии острого отравления пестицидами, содержащими фосфорорганические соединения, относятся:
112. Критериями эффективности патогенетической терапии острого отравления пестицидами, содержащими фосфорорганические соединения, являются:
113. К никотиноподобным симптомам при остром отравлении пестицидами, содержащими фосфорорганические соединения, относятся:
114. Какая классификация пестицидов (сельскохозяйственных ядохимикатов) является наиболее распространенной в настоящее время?:
115. Какие клинические симптомы характерны для острой интоксикации хлорорганическими пестицидами (ХОС)?
117. При вибрационной болезни дифференциальный диагноз необходимо проводить со всеми заболеваниями, кроме:
118. Для периферического ангиодистонического синдрома верхних конечностей при вибрационной болезни от локальной вибрации не характерно:
123. Какие симптомы характерны для стенозирующего лигаментита тыльной связки запястья по ходу I пальца (болезнь де Кервена)?:
125. Какие неотложные мероприятия нужно провести у больного с острым отравлением оксидом углерода средней тяжести?
126. К клиническим проявлениям острой интоксикации монооксидом углерода средней тяжести можно отнести:
127. Какие из перечисленных мероприятий противопоказаны при токсическом отеке легких (при гипокапническом типе гипоксии)?
128. Какие органы и системы страдают преимущественно при острых интоксикациях пестицидами из группы хлорорганических соединений (ХОС)?:
129. Характерные клинические симптомы острой интоксикации легкой степени пестицидами из группы фосфорорганических соединений (ФОС):
А. установление группы инвалидности профессионального характера после перенесенной интоксикации средней степени тяжести;
В. установление группы инвалидности профессионального характера после перенесенной тяжелой интоксикации пестицидами.
137. Для лечения больных с тяжелой формой отравления фосфорорганическими отравляющими веществами можно ли применять раствор эфедрина (5% - 0,5 мл.) внутривенно?
138. Извещение о подозрении на острое профессиональное заболевание (предварительный диагноз) направляется из медицинского учреждения в территориальное управление Роспотребнадзора и работодателю в течение:
139. Извещение о подозрении на хроническое профессиональное заболевание (предварительный диагноз) направляется из медицинского учреждения в территориальное управление Роспотребнадзора в течение:
140. Извещение о заключительном диагнозе острого или хронического профессионального заболевания специализированное профпатологическое учреждение направляет в территориальное управление Роспотребнадзора, работодателю, страховщику и в учреждение здравоохранения, направившего больного, в течение:
141. При получении извещения о предварительном диагнозе острого профессионального заболевания территориальное управление Роспотребнадзора представляет в учреждение здравоохранения санитарно-гигиеническую характеристику условий труда в течение:
142. При получении извещения о предварительном диагнозе хронического профессионального заболевания территориальное управление Роспотребнадзора представляет в учреждение здравоохранения санитарно-гигиеническую характеристику условий труда в течение:
А. оказание квалифицированной специализированной медицинской помощи прикрепленному контингенту с целью снижения общей и профессиональной заболеваемости, производственного травматизма, трудопотерь по болезни и инвалидности;
В. разработка и осуществление совместно с администрацией предприятия и по согласованию с органами Роспотребнадзора мероприятий по оздоровлению работающих;
А. проведение мероприятий по предупреждению и снижению заболеваемости, в том числе с временной утратой трудоспособности, инвалидности работающих;
Б. проведение лечебных и реабилитационных мероприятий, направление пациентов на консультацию и госпитализацию;
Г. анализ общей и профессиональной заболеваемости, производственного травматизма, инвалидности и участие в разработке мероприятий по их снижению, а также комплекса профилактических и оздоровительных мероприятий на предприятии;
А. оказание первой врачебной помощи при травмах, острых отравлениях и заболеваниях, аварийных ситуациях;
Б. проведение амбулаторного приема, лечение и реабилитация больных и инвалидов, организация консультации специалистов и госпитализации в стационар, экспертиза временной нетрудоспособности;
В. динамическое наблюдение за состоянием здоровья хронических больных, а также лиц, работающих в условиях профессиональных вредностей и неблагоприятных условий труда, профилактика и своевременное выявление общих и профессиональных заболеваний;
Г. координация и проведение периодических медицинских осмотров с последующим оформлением заключений о профпригодности;
А. проведение анализа общей и профессиональной заболеваемости и производственного травматизма и участие в разработке мероприятий по их снижению;
Б. проведение санитарно-просветительной работы, пропаганды здорового образа жизни, обучение работающих методам само- и взаимопомощи;
В. ведение учетно-отчетной документации и представление ее главному врачу учреждения здравоохранения или органам управления здравоохранения;
Г. разработка и проведение мер по профилактике и снижению профессиональной заболеваемости и трудопотерь по болезни и инвалидности;
А. диагностика профзаболеваний, лечение, реабилитация и наблюдение больных профессиональными заболеваниями и инвалидов вследствие профзаболеваний;
Б. контроль за качеством предварительных и периодических медицинских осмотров и реализацией профилактических и оздоровительных рекомендаций в соответствии с актом заключительной комиссии, а также проведение периодического медицинского осмотра в условиях стационара по расширенной программе с выдачей рекомендаций лечебно-профилактического характера;
В. организационно-методическое руководство по вопросам профпатологии в территории, разработка методических рекомендаций по профилактике, диагностике, лечению и реабилитации больных с профессиональными заболеваниями и инвалидов вследствие профзаболеваний;
Г. учет и углубленный анализ профессиональной заболеваемости и инвалидности вследствие профзаболеваний, разработка совместно с администрацией территории и органами Роспотреб надзора мероприятий по их профилактике и снижению;
А. проведение анализа состояния здоровья трудящихся, влияния вредных производственных факторов и разработка научно обоснованных рекомендаций по оздоровлению работающих;
Б. разработка мер по медицинской и социальной реабилитации больных профессиональными заболеваниями и инвалидов труда;
В. анализ деятельности профпатологической службы Федерации и общей лечебной сети по вопросам оказания медицинской помощи работающим и профилактики профзаболеваний и инвалидности;
Г. проведение в наиболее сложных и конфликтных ситуациях экспертизы связи заболевания с профессией и представление материалов на заключение Федерального Экспертного Совета;
Б. проверять работу территориальных органов и учреждений здравоохранения предприятий и организаций промышленности, строительства, транспорта, связи;
В. вносить предложения по улучшению медицинской помощи и контролю за состоянием здоровья трудящихся, формированию целевых территориальных и отраслевых программ;
Г. использовать в пределах 10% имеющегося коечного фонда клиник для диагностики и лечения больных профессиональными заболеваниями в особо сложных конфликтных ситуациях;
Г. участие в организации и проведение мер по улучшению санитарно-гигиенических условий труда работающих на производстве;
А. консультативный прием больных профессиональными заболеваниями, инвалидов вследствие профзаболеваний и лиц с подозрением на профзаболевания, госпитализация и курация больных в отделениях профпатологического стационара;
Б. диагностика профзаболеваний, лечение и реабилитация больных профзаболеваниями и инвалидов вследствие профзаболеваний;
В. выдача медицинских заключений по результатам консультации и рекомендаций для лечения врачами по месту жительства, по трудоустройству и ведению указанных больных и инвалидов, направление больных и инвалидов на МСЭК;
Г. клинико-экспертная оценка качества проведения предварительных и периодических медицинских осмотров работающих;
А. определение соответствия (пригодности) состояния здоровья рабочих и служащих поручаемой им работе;
А. динамическое наблюдение за состоянием здоровья работающих в условиях профессиональных вредностей и неблагоприятных условий труда;
Г. выявление заболеваний для предупреждения несчастных случаев и обеспечения безопасности труда, охраны здоровья населения;
159. Заключение о профессиональной пригодности поступающего на работу после предварительного медицинского осмотра выдает:
163. К категории безусловно профессиональных заболеваний относятся: 1) антракоз; 2) экзема; 3) варикозное расширение вен нижних конечностей; 4) вибрационная болезнь; 5) хронический бронхит:
164. Заключительный диагноз острого профессионального заболевания имеют право установить следующие медицинские учреждения:
165. Заключительный диагноз хронического профессионального заболевания имеют право установить все нижеуказанные медицинские учреждения, кроме:
166. Документами, необходимыми для решения вопроса о связи заболевания с профессией при направлении больного в специализированное профпатологическое учреждение, являются все перечисленные, кроме:
Д. подробной выписки из медицинской карты амбулаторного больного с результатами предварительного и периодических медицинских осмотров и выписки из истории болезни, если больной находился на стационарном лечении.
Хроническое отравление мышьяковистым водородом. Отравление фенилгидразином
Хроническое отравление мышьяковистым водородом. Отравление фенилгидразином
Хронические отравления мышьяковистым водородом в эксперименте на крысах при круглосуточном ингаляционном воздействии в концентрации 0,3 мг/м в течение 3 мес характеризовались метгемоглобинемией, падением уровня гемоглобина и SH-групп крови, реактивными изменениями РЭС, селезенки и печени, что, безусловно, сопряжено с гемолитической активностью. У человека при хроническом отравлении мышьяковистым водородом наряду с симптомами анемии развиваются симптомы, свидетельствующие о желудочно-кишечных расстройствах, а также признаки нарушения функционального состояния нервной системы в виде головокружений, болей в конечностях, шее, груди, животе, спине, онемения пальцев рук и ног Возможны изменения ЭКГ. Описанные явления протекают на фоне сдвигов общего характера в виде повышенной утомляемости, исхудания.
Механизм гемолитического действия нафталина близок к таковому свойственному мышьяковистому водороду. Поражение крови по типу гемолиза под влиянием нафталина характерно только при хроническом отравлении. При этом, помимо признаков гемолиза, появляются тельца Гейнца, развивается лейкоцитоз.
При подостром воздействии нафталина на крыс в дозах 0,2—0,004 LD50 снижалось число эритроцитов, появлялся ретикулоцитоз, наблюдалась полихромазия. По другим данным, даже при массивных повторных воздействиях картина крови существенно не менялась. В отличие от этого в условиях хронической ингаляции насыщенными парами нафталина в течение 2—5 мес круглосуточно у кроликов имело место сначала повышение, а затем снижение числа эритроцитов (при неизмененном содержании гемоглобина), что характерно для внутрисосудистого гемолиза. Одновременно с этим наблюдались пойкило- и анизоцитоз, полихромазия и базофильная зернистость, а также лейкоцитоз. У работающих в контакте с нафталином изменения со стороны крови носили аналогичный характер с тем различием, что содержание гемоглобина снижалось, появлялась тромбоцитопения, а лейкоцитоз сопровождался лимфоцитозом. Примечательно, что при хронической интоксикации нафталином развивались не только признаки гемолиза, но и достаточно характерным было помутнение хрусталика с появлением катаракты.
Отравление фенилгидразином
К гемолитикам-ингибиторам фермента Г-6-ФДГ относятся прежде всего фенилгидразин и его производные.
Клиника как острого, так и хронического отравления фенилгидразином в эксперименте на животных и согласно наблюдениям на людях представляет собой картину классического гемолитического состояния. Так, при воздействии на кроликов и крыс снижается в первую очередь число эритроцитов, значительно (в 4 раза) увеличивается количество ретикулоцитов, падает уровень гемоглобина, в 3—4 раза возрастает содержание метгемогло-бина. В условиях хронического эксперимента на крысах сначала возрастает, а затем падает активность фермента Г-6-ФДГ, аналогична динамика изменения содержания SH-групп крови.
У людей острое отравление фенилгидразином характеризуется с самого начала анемией с высоким ретикулоцитозом и билирубинемией за счет непрямой фракции, т.е. типичными признаками гемолиза. При этом появляются желтушность кожных покровов, цианоз губ, моча приобретает цвет пива, печень и особенно селезенка увеличиваются в размерах, в области правого подреберья — болезненность. Все это протекает на фоне общих неспецифических симптомов интоксикации — слабости, головной боли, головокружения, тошноты.
Хроническое отравление фенилгидразином у людей протекает со снижением числа эритроцитов и уровня гемоглобина, ретикуло- и пойкилоцитозом, появлением телец Гейнца, спленомегалией.
Среди ядов-гемолитиков высокой гемолитической активности, которая сочетается с метгемоглобинобразованием, обладает гидроперекись изопропилбензола (гипериз). Механизм гемолиза под влиянием гипериза обусловлен угнетением ферментов, содержащих SH-группы, включая снижение активности ряда дегидрогеназ. Гипериз обладает также свойствами окислителя, вызывая образование метгемоглобина, при условии замедленного его восстановления.
У животных (мышеи) резкий гемолиз вплоть до полного исчезновения эритоцитов и вызванная этим почечная недостаточность возникали при введении гидроперекиси изопропилбензола в брюшную полость. При действии гипериза на работающих в контакте с ним отмечено снижение содержания гемоглобина, числа эритроцитов, лейкоцитов, а также уровня SH-групп крови.
Информация на сайте подлежит консультации лечащим врачом и не заменяет очной консультации с ним.
См. подробнее в пользовательском соглашении.
Публикации в СМИ
Мышьяк и его соединения (мышьяковистый ангидрид, мышьяковистая кислота и её соли, мышьяковистый водород, сальварсан, осарсол, гербициды, «парижская зелень», пестициды) вызывают отравление, попадая в организм при вдыхании, всасываясь из ЖКТ и с поверхности кожи. Отравление мышьяком может быть острым или хроническим. В производственных условиях (химическая, кожевенная, меховая промышленности; протравливание зерна, применение пестицидов) наблюдают в основном хронические формы интоксикации, обычно в виде сенсорных (реже смешанных) форм полиневропатий.
Этиопатогенез • Энтеротоксическое (при приёме внутрь), нейротоксическое (диффузные дистрофические изменения более выражены в передних и боковых рогах спинного мозга и периферических нервах), гемолитическое (и связанные с ним поражение почек и печени) действие • Трёхвалентный мышьяк (As3+) связывается с тиоловыми группами ферментов и других белков в тканях • При хроническом отравлении мышьяк обычно накапливается в тканях, содержащих большое количество сульфгидрильных групп (ногти, волосы).
Клиническая картина
• Острое отравление: артериальная гипотензия, повышение проницаемости капилляров, мышечные спазмы, головокружение, гемолиз с развитием гемоглобинурии, желтухи, гемолитической анемии, острой почечно-печёночной недостаточности •• При приёме внутрь — жжение в горле, металлический привкус во рту, рвота (рвотные массы зеленоватого цвета), сильная боль в животе. Профузная диарея, напоминающий рисовый отвар, иногда с кровью. Резкое обезвоживание организма с хлорпеническими судорогами •• При ингаляции мышьяковистого водорода — спазм гортани, бронхоспазм, возможен отёк лёгких, метгемоглобинемия (цианоз), очень быстро развивается тяжёлый гемолиз, острая почечно-печёночная недостаточность (на 2–3 сут) •• В тяжёлых случаях (паралитическая форма отравления) — сопор, судороги, потеря сознания, паралич дыхания, кома, коллапс.
• Хроническое отравление: стойкое расширение капилляров, недомогание, повышенная утомляемость, анемия; возможны энцефалопатия, периферические невриты с потерей чувствительности; характерны жгучая боль, парестезии, реже слабость в конечностях, возможна гипотрофия мелких мышц; гиперкератозы, выпадение волос; на ногтях пальцев рук и ног появляются белые поперечные полосы (полоски Маеса); токсический гепатит. К мышьяку может развиться толерантность.
ЛЕЧЕНИЕ
Режим • При интоксикации лёгкой степени — лечение в амбулаторных условиях • При интоксикации средней тяжести — в условиях стационара • При трудоустройстве исключают контакт с токсическими веществами.
Тактика ведения • Рвотные средства, промывание желудка через зонд, повторные сифонные клизмы • При отравлении мышьяковистым водородом — непрерывная ингаляция кислорода • Показан ранний гемодиализ с одновременным введением антидотов, обменное переливание крови • Инфузионная и противошоковая терапия, форсированный диурез • Симптоматическая терапия: при резкой боли в кишечнике — спазмолитические средства (платифиллин, атропин); при гемоглобинурии — глюкозо-прокаиновая смесь (500 мл 5% р-ра глюкозы, 50 мл 2% р-ра прокаина), аминофиллин, натрия гидрокарбонат (1 л 4% р-ра) в/в, сердечно-сосудистые средства, лечение печёночной и почечной недостаточности • Специфическая (антидотная) терапия •• Димеркаптопропансульфоната натрия 5% р-р 150–200 мл в/в капельно или по 5 мл в/м каждые 6–8 ч •• Тетацин-кальций (30 мл 10% р-ра на 500 мл 5% р-ра глюкозы) в/в капельно.
Прогноз • Достаточно серьёзный (особенно при отравлении мышьяковистым водородом, смерть может наступить в течение первого часа в результате паралича дыхания) • Смертельная доза мышьяка при приёме внутрь 0,1–0,2 г.
МКБ-10 • T57.0 Токсическое действие мышьяка и его соединений
Код вставки на сайт
Отравление мышьяком
Мышьяк и его соединения (мышьяковистый ангидрид, мышьяковистая кислота и её соли, мышьяковистый водород, сальварсан, осарсол, гербициды, «парижская зелень», пестициды) вызывают отравление, попадая в организм при вдыхании, всасываясь из ЖКТ и с поверхности кожи. Отравление мышьяком может быть острым или хроническим. В производственных условиях (химическая, кожевенная, меховая промышленности; протравливание зерна, применение пестицидов) наблюдают в основном хронические формы интоксикации, обычно в виде сенсорных (реже смешанных) форм полиневропатий.
Этиопатогенез • Энтеротоксическое (при приёме внутрь), нейротоксическое (диффузные дистрофические изменения более выражены в передних и боковых рогах спинного мозга и периферических нервах), гемолитическое (и связанные с ним поражение почек и печени) действие • Трёхвалентный мышьяк (As3+) связывается с тиоловыми группами ферментов и других белков в тканях • При хроническом отравлении мышьяк обычно накапливается в тканях, содержащих большое количество сульфгидрильных групп (ногти, волосы).
Клиническая картина
• Острое отравление: артериальная гипотензия, повышение проницаемости капилляров, мышечные спазмы, головокружение, гемолиз с развитием гемоглобинурии, желтухи, гемолитической анемии, острой почечно-печёночной недостаточности •• При приёме внутрь — жжение в горле, металлический привкус во рту, рвота (рвотные массы зеленоватого цвета), сильная боль в животе. Профузная диарея, напоминающий рисовый отвар, иногда с кровью. Резкое обезвоживание организма с хлорпеническими судорогами •• При ингаляции мышьяковистого водорода — спазм гортани, бронхоспазм, возможен отёк лёгких, метгемоглобинемия (цианоз), очень быстро развивается тяжёлый гемолиз, острая почечно-печёночная недостаточность (на 2–3 сут) •• В тяжёлых случаях (паралитическая форма отравления) — сопор, судороги, потеря сознания, паралич дыхания, кома, коллапс.
• Хроническое отравление: стойкое расширение капилляров, недомогание, повышенная утомляемость, анемия; возможны энцефалопатия, периферические невриты с потерей чувствительности; характерны жгучая боль, парестезии, реже слабость в конечностях, возможна гипотрофия мелких мышц; гиперкератозы, выпадение волос; на ногтях пальцев рук и ног появляются белые поперечные полосы (полоски Маеса); токсический гепатит. К мышьяку может развиться толерантность.
ЛЕЧЕНИЕ
Режим • При интоксикации лёгкой степени — лечение в амбулаторных условиях • При интоксикации средней тяжести — в условиях стационара • При трудоустройстве исключают контакт с токсическими веществами.
Тактика ведения • Рвотные средства, промывание желудка через зонд, повторные сифонные клизмы • При отравлении мышьяковистым водородом — непрерывная ингаляция кислорода • Показан ранний гемодиализ с одновременным введением антидотов, обменное переливание крови • Инфузионная и противошоковая терапия, форсированный диурез • Симптоматическая терапия: при резкой боли в кишечнике — спазмолитические средства (платифиллин, атропин); при гемоглобинурии — глюкозо-прокаиновая смесь (500 мл 5% р-ра глюкозы, 50 мл 2% р-ра прокаина), аминофиллин, натрия гидрокарбонат (1 л 4% р-ра) в/в, сердечно-сосудистые средства, лечение печёночной и почечной недостаточности • Специфическая (антидотная) терапия •• Димеркаптопропансульфоната натрия 5% р-р 150–200 мл в/в капельно или по 5 мл в/м каждые 6–8 ч •• Тетацин-кальций (30 мл 10% р-ра на 500 мл 5% р-ра глюкозы) в/в капельно.
Прогноз • Достаточно серьёзный (особенно при отравлении мышьяковистым водородом, смерть может наступить в течение первого часа в результате паралича дыхания) • Смертельная доза мышьяка при приёме внутрь 0,1–0,2 г.
МКБ-10 • T57.0 Токсическое действие мышьяка и его соединений
Интоксикации ядами гемолитического действия
Среди разнообразных промышленных ядов выделяют группу токсичных веществ, обладающих способностью вызывать повреждение эритроцитов, т.е. оказывать гемолитическое действие.
Гемолитические анемии — разнообразная группа заболеваний, объединяемая одним общим признаком — укорочением продолжительности жизни эритроцитов или эритрокариоцитов.
Следствием этих изменений является та или иная степень анемии, раздражение эритропоэза, ретикулоцитоз.
Гемолитические анемии делятся на наследственные и приобретенные.
Наследственные гемолитические анемии можно дифференцировать по локализации поражения: мембраны эритроцита, его ферментов, структуры гемоглобина [Идельсон Л.И., 1985].
Приобретенные гемолитические анемии разделяются по принципу уточнения фактора, вызывающего гемолиз:
- наличие антител,
- механическая травма эритроцитов,
- химические яды.
Среди последних выделяют вещества, оказывающие прямое непосредственное гемолитическое действие, выраженность которых определяется уровнем временем воздействия, путями проникновения в организм.
Приобретенные гемолитические анемии вследствие интоксикации химическими веществами.
Мышьяковистый водород:
тяжелый бесцветный газ, в производственных условиях его образование происходит при воздействии технических кислот на металлы и соединения, содержащие мышьяк.
водород, образующийся в ходе реакции, восстанавливает элементарный мышьяк, при его распаде образуется диэтиларсин, вследствие чего появляется характерный чесночный запах.
ПДК мышьяковистого водорода 0,3 мг/м3.
основной путь поступления в организм — ингаляционный
Фенилгидразин:
используют в фармацевтической промышленности для изготовления препаратов (пирамидон).
ПДК производных гидразина 0,1 мг/м3.
Толуилендиамин:
в производстве красителей и некоторых полимерных соединений.
ПДК 2 мг/м.
Гидроперекись изопропилбензола (гипериз):
катализатор в производстве полиэфирных и эпоксидных смол, каучуков, стеклопластиков и др.;
промежуточный продукт в производстве фенола и ацетона.
ПДК 1 мг/м3.
Острый внутрисосудистый гемолиз могут вызвать при приеме внутрь:
- уксусная эссенция,
- бертолетова соль,
- ядовитые грибы
- функциональными и структурными изменениям гемоглобина,
- необратимым сдвигам в липидах мембран эритроцита
- ингибированию активности сульфгидрильных групп
Патоморфологические изменения различаются в зависимости от времени наступления и причин смерти:
- умершие в ближайшие сроки после отравления от резкого кислородного голодания вследствие массового распада эритроцитов – это «острая смерть» или «аноксемическая смерть»;
- умершие в более поздние сроки при явлениях олигурии, часто анурии, т.е. от тяжелых изменений в почках – это «смерть в подостром периоде»
Патологическая анатомия
Наиболее выраженные микроскопические изменения обнаруживаются в почках, что обусловлено гемоглобин- и гемосидеринурией и скоплением больших масс распавшихся эритроцитов.
Кожа приобретает различной интенсивности желтовато-бронзовую окраску, желтушность менее выражена в более поздние сроки смерти.
Кровь имеет темно-красный цвет (действие гемолитического яда).
Отмечается различной степени выраженности отек слизистых оболочек полости рта, гортани, отек легких, вещества мозга.
В печени и селезенке - значительное отложение железа.
В случае смерти в подостром периоде, помимо отека и дистрофических изменений в нервных клетках, обнаруживаются мелкие кровоизлияния, выраженная нейронофагия.
Клиника острых внутрисосудистых гемолитических анемий при интоксикации наиболее типичным представителем этой группы – мышьяковистым водородом.
Скрытый период - 2—8 ч, хотя гемолиз начинается сразу после поступления яда в организм.
Легкие формы интоксикации АrНз характеризуются скудной клинической симптоматикой:
слабость, головная боль, тошнота, небольшой озноб; возможна легкая желтушность склер.
затем следует период прогрессирующего гемолиза:
нарастание общей слабости, головной боли,
боли в эпигастральной области и правом подреберье, в пояснице с тошнотой, рвотой, лихорадкой
моча приобретает темно-красный цвет (гемоглобин- и гемосидеринурии) - гемоглобинурия является первым признаком отравления
Как правило, при этих формах больные в стационар поступают только в случае групповых интоксикаций.
При развитии выраженного гемолиза:
Лихорадка (38—39 °С).
Кровь:
снижение кол-ва Эр и Нв,
ретикулоцитоз до 200-300%,
увеличение Эр с базоффильной зернистостью,
нейтрофильный лейкоцитоз со сдвигом влево,
иногда лимфо- и эозинопения
изменения в моче:
гемоглобинурия,
значительная протеинурия.
На 2—3-е сутки появляется желтуха, нарастает билирубинемия, на 3—5-е сутки – симптомы печеночной недостаточности (гепатомегалия, ферментемия)
В те же сроки развивается ОПН (олигурия, вплоть до анурии, азотемия с нарушением фильтрации, реабсорбции, экскреторной функции). В периоде нефропатии моча светлая, определяется только микрогематурия
При своевременном лечении отмечается регрессия симптомов почечной недостаточности и наступает период выздоровления, который продолжается от 4 до 6—8 нед.
Особенностью интоксикации АrНз является довольно длительное сохранение (иногда до полугода) некоторых нарушений:
- анемизация,
- полиневритический синдром,
- со стороны почек нарушение некоторых функциональных проб, иногда вплоть до развития пиелонефрита.
- на данных о загрязнении воздуха рабочей зоны АrНз
- характерной клинико-лабораторной симптоматике.
- имеет значение обнаружение мышьяка в биосредах и диализируемой жидкости.
В качестве антидотов к мышьяковистому водороду используют тиоловые соединения:
мекаптид 40 % раствор 1—2 мл внутримышечно до 5—7 мл/сут;
антарсин 5 % раствор 1 мл внутримышечно;
унитиол 5 % раствор внутривенно капельно на 10% растворе глюкозы от 50 до 150 мл в сутки
Для лечения гемолиза используют введение гипертонического (10—20 %) раствора глюкозы и 4 % раствора гидрокарбоната натрия для коррекции ацидоза.
- маннитола, мочевины,
- лазикса.
- полиглюкин,
- гемодез,
- кокарбоксилазу, витамины группы В.
При тяжелых формах отравления, когда наблюдаются остаточные явления интоксикации (симптомы функциональной недостаточности печени, почек, анемия), необходимо прекращение контакта с веществами гемолитического действия.
На срок переквалификации возможно пенсионирование по профессиональной группе
Анемия хронических состояний. Хроническое отравление метгемоглобинобразователями. Показатели хронического отра

Хроническое отравление метгемоглобинобразователями. Показатели хронического отравления аминами
Показатели гемотоксического действия при хроническом отравлении метгемоглобинобразователями. Вопрос о развитии хронических отравлений под влиянием метгемоглобинобразователей из класса аминов и нитросоединений бензола долгое время оставался дискуссионным. На определенном этапе возможность развития хронического отравления, в частности анилином, вообще исключалась. По-видимому, такое ошибочное представление сложилось в связи с не изученными к тому времени и общеизвестными сейчас фактами привыкания к анилину, которое приводит к нормализации покателей крови даже в условиях продолжающегося воздействия яда, но справедливо оценивается как фаза хронической интоксикации.
Поэтому в настоящее время возможность возникновения хронических отравлений амино- и нитропроизводными бензола признана вполне реальной. В частности, описаны хронические профессиональные отравления анилином, р-нитроанилином, тринитротолуолом, р-нитрохлорбензолом с синдромом анемии. Есть данные о развитии анемии в результате длительного употребления фенацетина как лекарственного препарата.
Отличительная особенность анемии при хроническом отравлении ароматическими аминами и нитросоединениями — ее гипохромный характер сравнительно с гиперхромной анемией при остром отравлении. В остальном специфические изменения красной крови в целом аналогичны таковым, описанным выше применительно к острому отравлению, включая мет- и сульфгемоглобинемию, а также тельца Гейнца. Вместе с тем клиника поражения крови во многом зависит от фазы интоксикации. Например, хроническое отравление ароматическими аминами на ранних стадиях характеризуется возрастанием гемоглобина и числа эритроцитов, а затем уже развиваются явные признаки анемии с падением гемоглобина и эритроцитов.
Прослежены особенности течения хронических анемий в зависимости от того, какие конкретно соединения ее вызвали. Так, своеобразие анемии при хроническом воздействии нитрохлорбензола заключается в замедленном на начальном этапе, а затем бурном ее течении.

Грозным осложнением анемии при хронической интоксикации тринитротолуолом (ТНТ) может быть развитие в отдельных случаях апластических состояний, что совершенно нехарактерно для действия других веществ этого класса.
Помимо специфических изменений морфологического состава периферической крови в условиях хронического воздействия ароматических амино-и нитросоединений, известны и изменения ее биохимического состава. В частности, описаны разнонаправленные изменения в содержании негемоглобинового железа сыворотки как в сторону падения, так и в сторону повышения при хронической интоксикации ТНТ, что, по-видимому, обусловлено фазовостью ее течения. В эксперименте на животных прослежено увеличение содержания связанного трансферрина (сидерофидина), отождествляемого с транспортной формой железа, т.е. негемоглобиновым железом сыворотки, в условиях повторного воздействия анилина, нитробензола, р-нитроанилина и дихлорпаранитроанилина.
Такой сдвиг — вторичное проявление регенераторной анемии, которая неизбежно сопровождается усиленным транспортом железа из депо в костный мозг. Примечательно, что сдвиг в сторону гиперферримии на примере р-нитроанилина сочетался с повышением уровня железа в печени и особенно в селезенке (более чем в 4 раза по сравнению с контрольными цифрами). Подобные изменения можно объяснить тем, что резко выраженная гемолитическая анемия под влиянием р-нитроанилина приводит к избыточному депонированию железа в виде ферритина и гемосидерина не только в селезенке, но и в печени, прямым следствием поражения красной крови при хронической интоксикации метгемоглобинобразователями становится вовлечение в патологический процесс ретикулоэндотелиальной системы (РЭС), в результате чего развивается сплено- и гепатомегалия.
По данным Н.М.Василенко, среди испытанных в эксперименте на предмет поражения красной крови 46 веществ-метгемоглобинобразователей в 24 случаях имело место увеличение относительной массы селезенки, что сочеталось иногда с дефицитом витамина С в этом органе. Увеличение массы селезенки объясняется гемолитической природой анемии, когда продукты гемолиза утилизируются селезенкой, а в особо тяжелых случаях и купферовскими клетками печени со скоплением в этих органах гемосидерина и гематоидина, содержащих железо
Особое место при оценке длительного (подострого и хронического) воздействия аминов и нитросоединений ряда бензола следует отвести нарушениям обмена серосодержащих соединений, как правило, имеющих прямое отношение к механизму их токсического влияния.
- Читать далее "Метгемоглобинобразователи и серосодержание вещества. Иммунитет при воздействии метгемоглобинобразователей"
Оглавление темы "Отравление метгемоглобиобразователями":
1. Ароматические амины. Сульфгемоглобин
2. Тельца Гейнца. Образование телец Гейнца
3. Острое отравление метгемоглобинобразователями. Показатели гематотоксического действия
4. Хроническое отравление метгемоглобинобразователями. Показатели хронического отравления аминами
5. Метгемоглобинобразователи и серосодержание вещества. Иммунитет при воздействии метгемоглобинобразователей
6. Воздействие метгемоглобинобразователей на органы. Неорганические метгемоглобинобразователи
7. Первичный гемолиз. Механизм гемолиза при отравлении гемолитиками
8. Хроническое отравление мышьяковистым водородом. Отравление фенилгидразином
9. Угнетение ксенобиотиками системы кроветворения. Бензольная гемопатия
10. Периферическая кровь при бензольном отравлении. Лимфоидная ткань при воздействии бензола
Читайте также:
